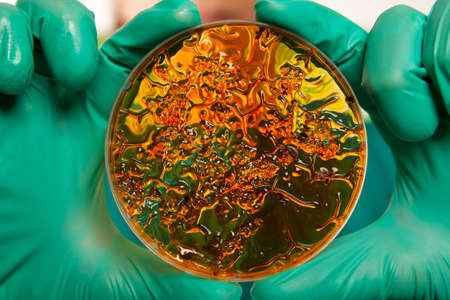
Scientist holding a petri dish with virus cellsの写真素材

写真素材 - Scientist holding a petri dish with virus cells
キーワード
- agents
- biochemistry
- biology
- cells
- cholera
- concept
- conditions
- controlled
- dish
- drugs
- ebola
- epidemic
- equipment
- experiments
- facility
- female
- fever
- flare
- flu
- gloves
- green
- growth
- hand
- health
- holding
- hygiene
- infection
- infectious
- lab
- laboratory
- life
- lights
- measure
- petri
- poison
- quarantine
- research
- results
- safety
- scientific research
- scientist
- symbol
- technology
- toxicant
- toxin
- virus
- work
- bacteria
類似作品
Portrait of a m...
Elegant waiters...
Male doctor ana...
Scientist exami...
Professional wa...
Hand in blue gl...
A focused resea...
Formal service ...
a scientist is ...
Close-up of che...
Scientist worki...
Talented chef i...
Waiter with a w...
Nurse carefully...
woman biologist...
Team Asian scie...
Making new disc...
Waiter's hand w...
scientist in a ...
A veterinarian ...
Focused scienti...
Female doctor h...
Chemical Labora...
Woman holding b...
Close up image ...
Hands with a wh...
Scientist pipet...
Chemical Labora...
A scientist in ...
Young businessm...
a doctor or res...
The female doct...
A person is tou...
Scientist inter...
satellite dish ...
plate in hand
A cleaner holds...
Young woman sci...
A microbiologis...
Portrait of a m...
scientist in a ...
Food safety ins...
A group of scie...
Medicine, scien...
Laboratory tech...
Close up of a f...
Young waiter se...
Senior scientis...
Preparing food ...